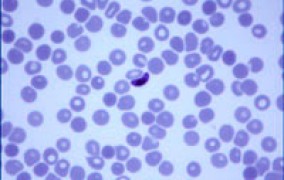

Busca - 39401 notícias encontradas
-
PD em modelagem climática com bolsa da FAPESP
26 de julho de 2011Projeto Temático no Inpe tem oportunidade de pós-doutoramento para desenvolver pesquisa em modelagem climática regional na América do Sul -
Instituto de Biologia da Unicamp ganha nova biblioteca
26 de julho de 2011Com modernas instalações, prédio abrigará um dos maiores acervos do país na área de ciências biológicas e biomédicas -
Fórum Internacional SPDM: Saúde em 2021
26 de julho de 2011Traçar cenários e discutir estratégias para os profissionais de saúde se prepararem para as mudanças na medicina nos próximos anos é o objetivo do evento -
Conferências USP – Química e Ciências da Terra
26 de julho de 2011Evento, realizado pela USP, terá a participação de três prêmios Nobel de Química -
Educação e risco cardiovascular
25 de julho de 2011Estudo realizado por pesquisadores da UFSCar com 1.116 indivíduos indica que prevalência de síndrome metabólica em São Carlos (SP) passa dos 35% e está diretamente associada a baixos níveis educacionais -
Nova lua para Plutão
25 de julho de 2011Telescópio espacial Hubble descobre quarta lua de Plutão – a menor de todas, com diâmetro estimado entre 13 e 34 quilômetros -
Prêmio para recém doutores em biologia molecular
25 de julho de 2011Estão abertas até 1º de agosto as inscrições para o GE & Science Prize for Young Life Scientists -
13º Simpósio de Iniciação Científica e Tecnológica
25 de julho de 2011Evento, promovido pela Fatec, tem o objetivo de promover a apresentação de trabalhos de pesquisa para alunos de graduação e pós-graduação -
18º Simpósio de Engenharia de Produção
25 de julho de 2011Sustentabilidade e cadeias produtivas será o tema do evento realizado pela Unesp de Bauru -
USP seleciona docentes
25 de julho de 2011Instituto de Química de São Carlos está com inscrições abertas de processos seletivos para contratação de professores temporários, titulares e doutores -
Inspirados na natureza
22 de julho de 2011Biodiversidade continua sendo fonte inesgotável de novas arquiteturas moleculares para o desenvolvimento de medicamentos, cosméticos e agroquímicos, atestam pesquisadores no Ciclo de Conferências do Ano Internacional da Química -
Revalorização da parasitologia
22 de julho de 2011Regina Franco, da Unicamp, destaca a necessidade de metodologias validadas internacionalmente e recursos humanos capacitados para aprimorar pesquisas sobre surtos causados por protozoários patogênicos -
Bolsas para Pesquisa em Biologia Integrada
22 de julho de 2011Agilent Technologies oferece oportunidade para dois pesquisadores, que receberão US$ 75 mil. As inscrições estarão abertas até o dia 12 de agosto -
Prêmio de Incentivo em Ciência e Tecnologia para o SUS
22 de julho de 2011Inscrições estarão abertas até o dia 29 de julho. Nova categoria “Acesso ao SUS”, terá premiação de R$ 15 mil -
2ª Conferência da Associação Brasileira de Pesquisa em Aerossol (BARR)
22 de julho de 2011Propriedades específicas, impactos ambientais e saúde pública serão alguns dos temas abordados no evento, que será realizado na PUC-Rio -
Food Chemicals Codex: Evolução dos Métodos Analíticos e a Prevenção da Adulteração para Alimentos
22 de julho de 2011Evento, promovido pela USP, visa apresentar um compêndio de padrões analíticos de qualidade para ingredientes alimentícios -
Dinâmica do exoesqueleto
21 de julho de 2011Estudo realizado com abelhas por grupo da USP amplia conhecimento sobre relação entre genes e hormônios que controlam processo de mudança do exoesqueleto dos insetos. Trabalho foi publicado na PLoS One -
PD em produção de álcool com Bolsa da FAPESP
21 de julho de 2011Projeto Temático "Geração de Cenários de Produção de Álcool como Apoio para a Formulação de Políticas Públicas Aplicadas à Adaptação do Setor Sucroalcooleiro Nacional às Mudanças Climáticas" tem oportunidade para pós-doutoramento na Unicamp -
Livro histórico de Vital Brazil é relançado
21 de julho de 2011Obra comemorativa do Instituto Butantan traz fac-símile da original “A Defesa Contra o Ophidismo”, do cientista Vital Brazil, analisada por 12 pesquisadores -
Exame reduz risco de mortalidade neonatal
21 de julho de 2011Estudo da Secretaria de Estado da Saúde mostra que Teste de Fibronectina Fetal ajuda a evitar partos prematuros e a mortalidade neonatal -
One-day Workshop on Cloud Computing
21 de julho de 2011Encontro da Unesp promoverá a divulgação da tecnologia para que as instituições de ensino e pesquisa possam criar suas próprias estruturas de cloud computing -
4º Simpósio de Restauração Ecológica
21 de julho de 2011Evento discutirá a metodologia e o desenvolvimento de modelos e ferramentas adequadas para a restauração de áreas degradadas, considerando-se as diversas situações e biomas ocorrentes no Brasil -
Mais álcool hidratado
20 de julho de 2011Pesquisadores conseguem aumentar em 11% o rendimento do etanol sobre a sacarose utilizando leveduras geneticamente modificadas, em nova alternativa para elevar a produção do biocombustível -
A nutrição de peixes e a fome mundial
20 de julho de 2011Professor da USP afirma que a aquicultura pode contribuir para reduzir o problema da fome no mundo, mas para isso precisa encontrar novas fontes de nutrientes para os peixes -
Unesco e governo do Japão oferecem bolsas de doutorado
20 de julho de 2011Estudantes de mestrado de todos os países podem se inscrever até o dia 13 de janeiro de 2012. Projetos devem ser desenvolvidos na área de Meio Ambiente, com foco em estudos relacionados à água -
Inpe lança site para comemorar 50 anos
20 de julho de 2011Novo site destaca principais fatos e realizações do Inpe, em suas diversas áreas de atuação, contextualizados a acontecimentos marcantes no Brasil e no mundo, na ciência e tecnologia -
Psicoterapia Analítica Funcional
20 de julho de 2011Palestra promovida pelo Instituto de Psicologia da USP será apresentada por Jonathan Kanter, professor da Universidade de Wisconsin (Estados Unidos), em São Paulo -
1ª Semana de Educação
20 de julho de 2011“Educação, escola e formação: a pedagogia em questão” será o tema do evento promovido pelos alunos do curso de Pedagogia da Escola de Filosofia, Letras e Ciências Humanas da Unifesp, em Guarulhos (SP) -
Sentido invertido
19 de julho de 2011Enquanto não supera gargalos para se tornar uma ferramenta para o desenvolvimento efetivo de novas drogas, a técnica conhecida como ODN reverso é usada para avançar o conhecimento sobre os mecanismos da dor, diz professor da Unicamp -
Pós-graduação em Saúde Pública
19 de julho de 2011Estão abertas até 2 de setembro as inscrições para o processo seletivo da pós-graduação da Faculdade de Saúde Pública da USP
Mais lidas do mês
-
Pesquisadoras descobrem nova espécie de microrganismo adaptado a frio e calor extremos na Antártida
01 de junho de 2026
-
Combinação de metais abundantes pode baratear produção de hidrogênio verde
02 de junho de 2026
-
Parceria científica entre Brasil e Argentina resiste a crises e fragmentação geopolítica
02 de junho de 2026
-
Relógio inteligente detecta ansiedade e estresse em tempo real
08 de junho de 2026
-
Brasil precisa superar gargalos ambientais e tecnológicos para viabilizar mineração de terras-raras
03 de junho de 2026
-
Novo modelo físico explica rotação retrógrada de Vênus como resultado natural da evolução planetária
01 de junho de 2026
-
Nanotecnologia brasileira permite tratar doenças de pele com precisão
03 de junho de 2026
-
FAPESP busca impulsionar colaboração científica entre São Paulo e o Reino Unido
01 de junho de 2026
-
FAPESP e Reino Unido abrem nova fase de cooperação científica em Londres
03 de junho de 2026
-
Inteligência artificial converte câmeras de segurança em sistemas de monitoramento ativo
02 de junho de 2026